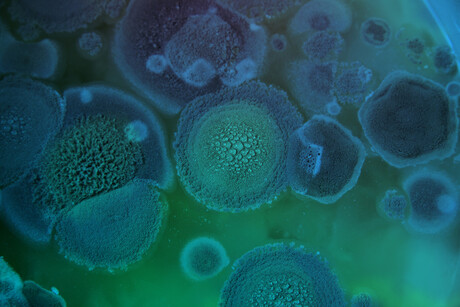
WHO releases list of health-threatening fungi

WHO releases list of health-threatening fungi
The World Health Organization (WHO) has published a report highlighting the first-ever list of fungal priority pathogens — a catalogue of the 19 fungi that represent the greatest threat to public health. The WHO fungal priority pathogens list (FPPL) is said to be the first global effort to systematically prioritise fungal pathogens, and aims to focus and drive further research and policy interventions to strengthen the global response to fungal infections and antifungal resistance.
Fungal pathogens are a major threat to public health as they are becoming increasingly common and resistant to treatment, with only four classes of antifungal medicines currently available and few candidates in the clinical pipeline. The invasive forms of these fungal infections often affect severely ill patients and those with significant underlying immune system-related conditions, including cancer, HIV/AIDS, organ transplants, chronic respiratory disease and post-primary tuberculosis infection.
Emerging evidence indicates that the incidence and geographic range of fungal diseases are both expanding worldwide due to global warming and the increase of international travel and trade. During the COVID-19 pandemic, the reported incidence of invasive fungal infections increased significantly among hospitalised patients. As the fungi that cause common infections (such as candida oral and vaginal thrush) become increasingly resistant to treatment, risks for the development of more invasive forms of infections in the general population are also growing.
That said, fungal infections receive very little attention and resources, leading to a scarcity of quality data on fungal disease distribution and antifungal resistance patterns. As a result, the exact burden of fungal diseases and antifungal resistance is unknown, and the response is therefore undermined.
The WHO FPPL list is divided into three categories — critical, high and medium priority — based on the pathogens’ public health impact and/or emerging antifungal resistance risk. The fungi of greatest concern on the list are the four critical priority pathogens:
- Aspergillus fumigatus, which mainly affects the lungs, is becoming increasingly resistant to azole medicines (a group of antifungals). Infections caused by azole-resistant strains kill 47–88% of affected patients.
- Candida albicans can cause invasive infections, typically in vulnerable patients, and kills 20–50% of people it affects.
- Cryptococcus neoformans has a propensity to infect the brain, especially in immunocompromised individuals. The main risk factor globally is HIV infection, and it is a leading killer in this population.
-
Candida auris is a newly emerged pathogen. It is resistant to most antifungal medications and presents a huge treatment challenge for hospitals. It is so environmentally tenacious that affected wards may have to be closed for prolonged periods to avoid transmission between patients.
The authors of the report stress the need for more evidence to inform the response to this growing threat and to better understand the burden — both of disease and antifungal resistance. The report also highlights the urgent need for coordinated action to address the impact of antifungal use on resistance across the One Health spectrum and calls for expanding equitable access to quality diagnostics and treatments.
The FPPL report underscores strategies for policymakers, public health professionals and other stakeholders, aimed at generating evidence and improving response to these fungal priority pathogens. The primary recommended actions are focused on strengthening laboratory capacity and surveillance; sustaining investments in research, development and innovation; and enhancing public health interventions for prevention and control.
To view the full report, click here.
Please follow us and share on Twitter and Facebook. You can also subscribe for FREE to our weekly newsletters and bimonthly magazine.
AusBiotech partners with Tenmile
Designed to support Australia's homegrown life sciences innovation, AusBiotech has announced...
Australian CDC issues update in wake of Ebola outbreak
After the WHO determined the outbreak of Ebola in the DRC and Uganda to be a public health...
Australia announces $7.2m diphtheria outbreak response package
To respond to the biggest diphtheria outbreak on record, support has been announced for the NT...



